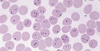
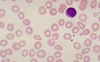
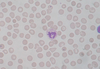
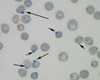
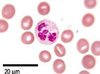
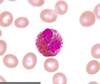
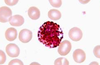
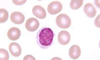
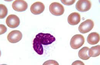
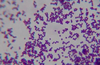
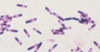

Microscopy Flashcards
(19 cards)

Thalassemia

What condition is highlighted int the blood film
Malaria
What condition is highlighted int the blood film
Describe what you see and what is the an indicator of
What are these how are they distinguished from Howell jolly bodies and what are they indicative of
What type of white bloood cell is this
What type of whit blood cell is this
Granulocyte
What type of white blood cell is this
What type of white blood cell is this
What type of whit blood cell is this
Describe what this gram stain shows

Describe what the gram stain shows
What does the gram stain show

Gram possitive streptococci
Descirbe what is shown in this gram stain

Longstrains of gram possitive cocci (strep
Describe what is shown in the gram stain
Describe what is shown in the gram stain

Des caribe the gram stain

Describe the gram strain


